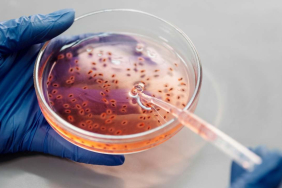

Kongo Demokratik Cumhuriyeti’nin (KDC) doğusundaki Ituri eyaletinde, isyancı grubun saldırısında, ilk belirlemelere göre, 55 sivil hayatını kaybetti.
Ulusal basındaki haberlere göre, Kongo’nun Kalkınması İttifakı (CODECO) adlı isyancı grup üyeleri, Ituri eyaletinin Djugu bölgesindeki birkaç köyde sivillere yönelik silahlı saldırı düzenledi.
CODECO üyelerinin ağır silahlar kullandığı saldırıda, ilk belirlemelere göre 55 sivil yaşamını yitirdi.
İsyancılar, birçok evi ateşe verdikten sonra bölgeden uzaklaştı.
2019’dan bu yana saldırılarını yoğunlaştıran CODECO’nun saldırılarında binlerce sivil hayatını kaybetti, yüzbinlerce kişi yerinden edildi.
Birleşmiş Milletler’in savaş suçları işlemekle suçladığı CODECO’nun, katliam, yağmalama, tecavüz ve fidye amaçlı adam kaçırma gibi insan hakları ihlalleri yaptığı belirtiliyor.
KDC’nin Ruanda, Uganda ve Burundi sınırının bulunduğu doğusu, 20 yıldır altın ve kobalt gibi madenlerin kontrolünü sağlamaya çalışan silahlı grupların saldırılarına ve çatışmalarına sahne oluyor.

Dört duvar arasına sıkışan, bilgisayarla yaşayan, e-postalar ile boğuşan beyaz yakalıların dünyası.